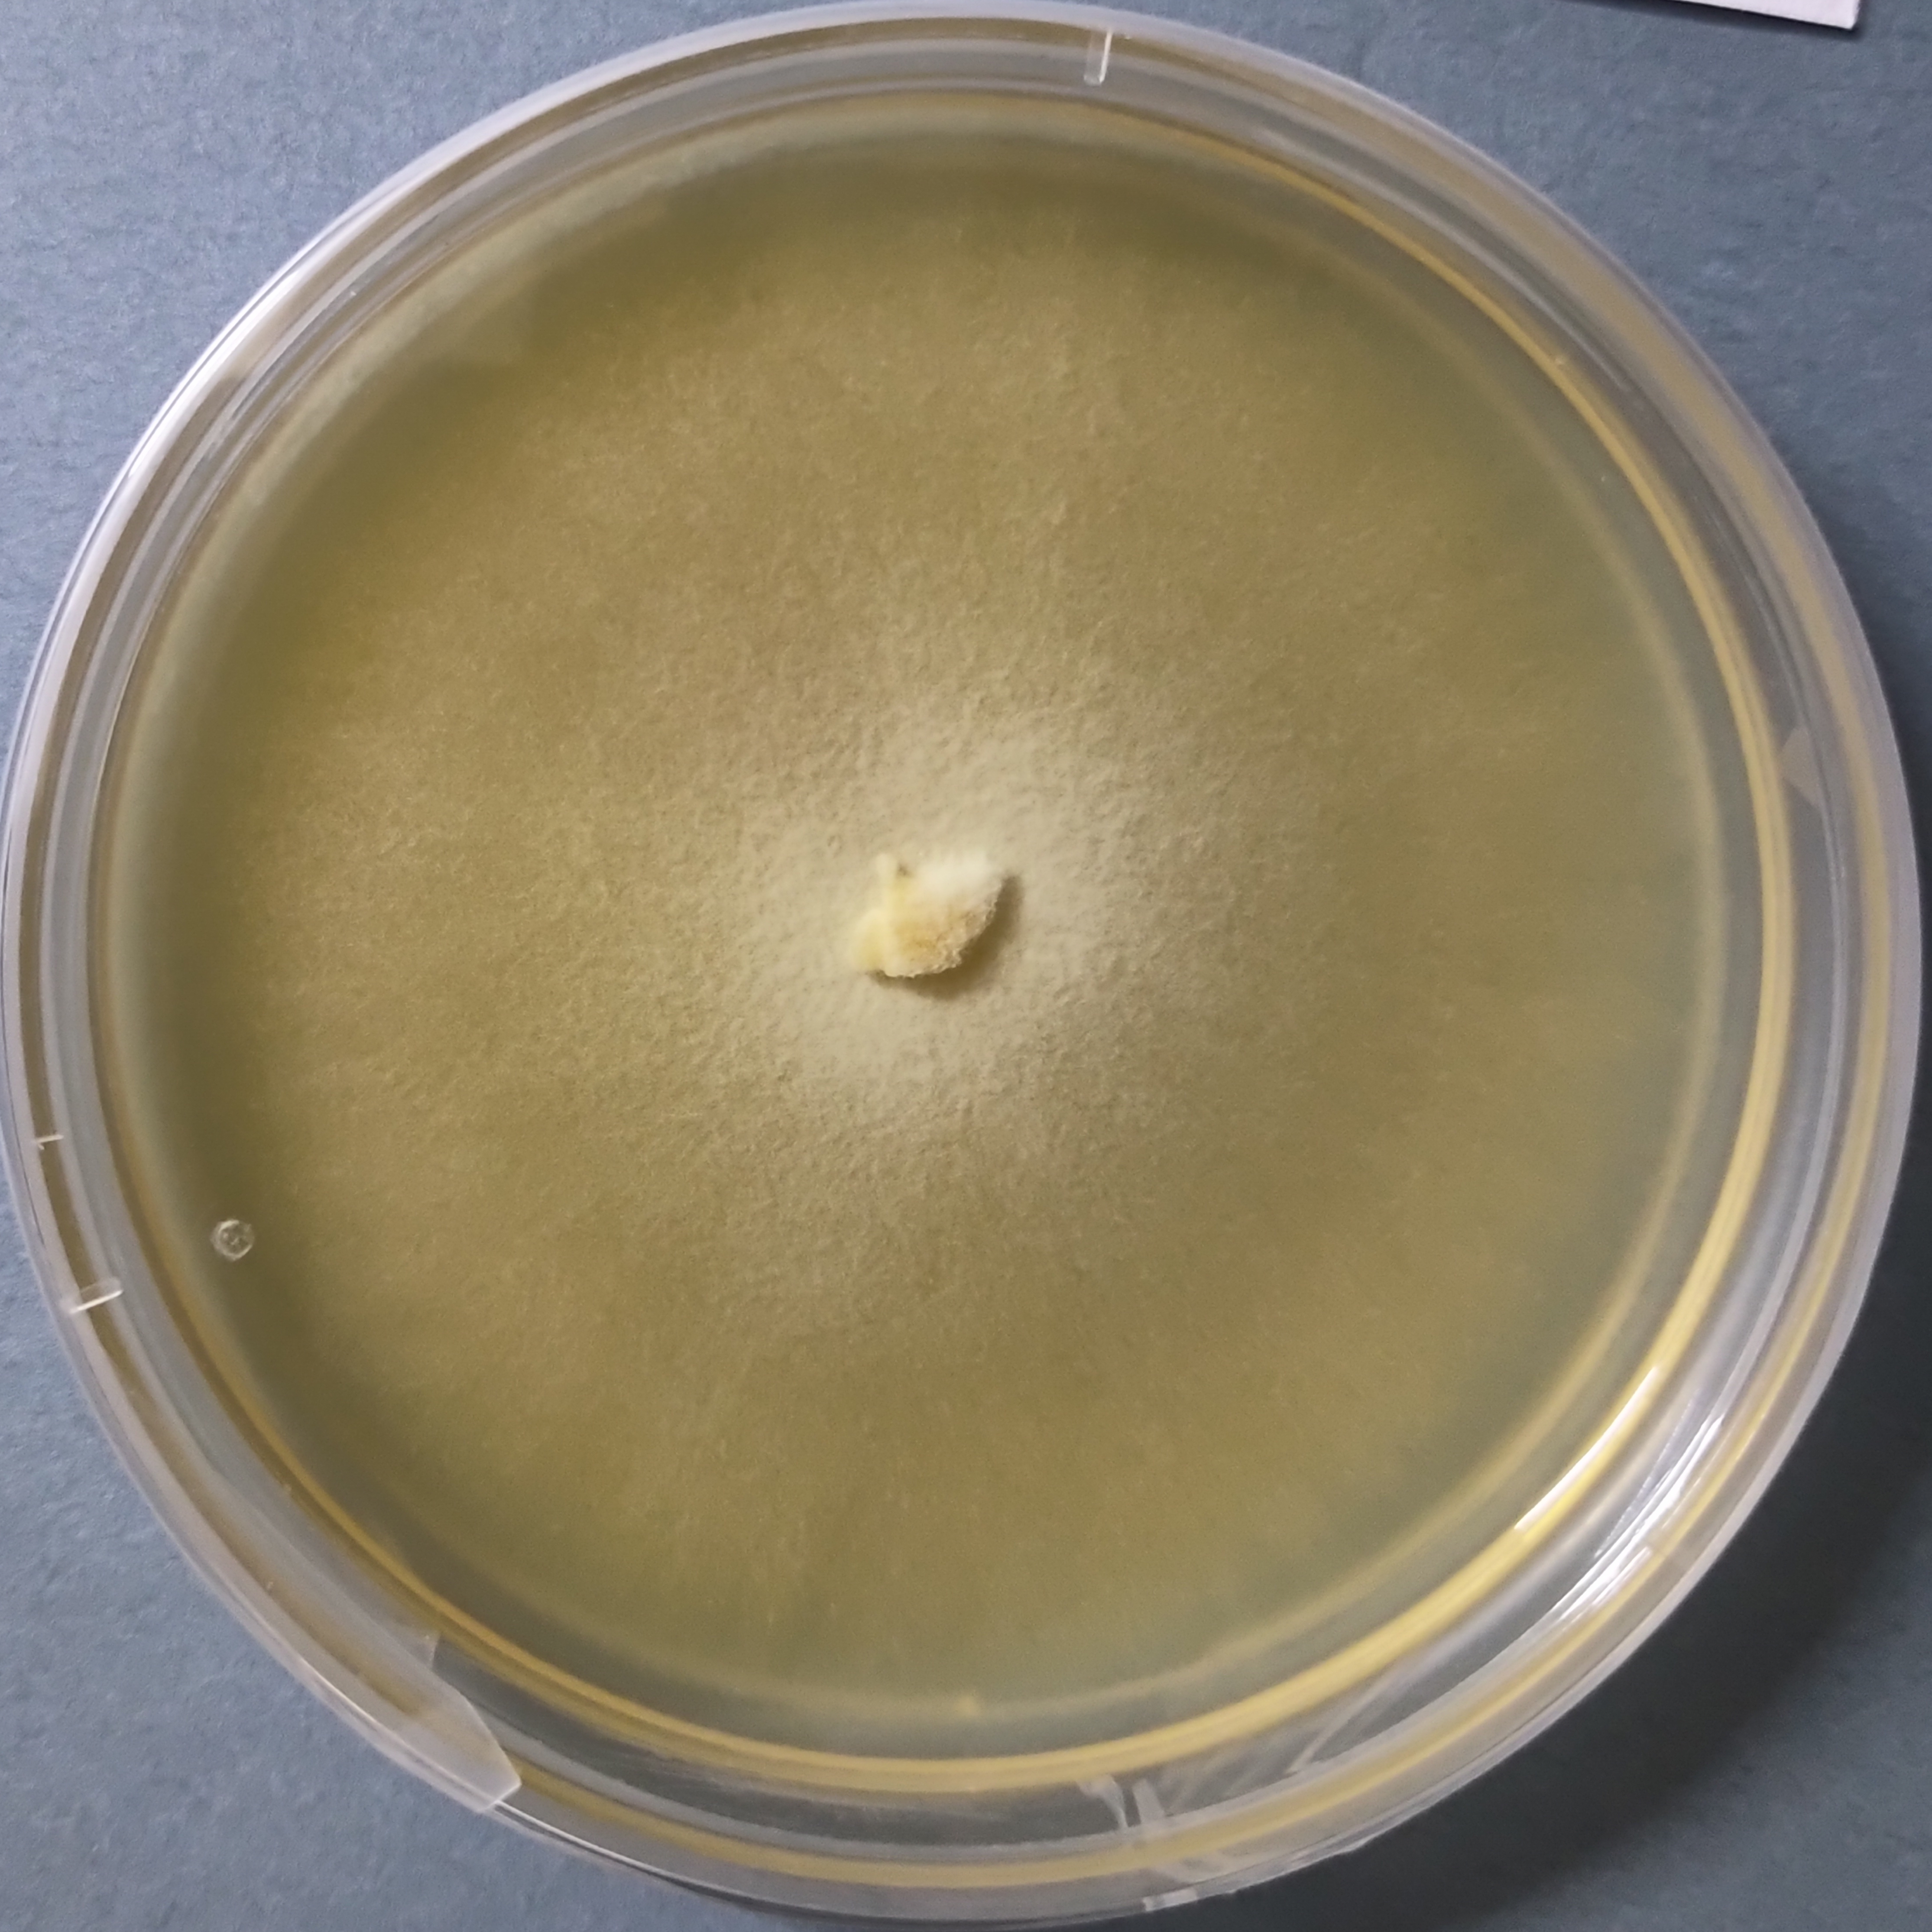
Pholiota nameko Pure Culture (Nameko Mushroom)

Cordyceps Mushroom Powder Keeda Jadi mushroom Powder
₹1,100.00 – ₹6,125.00Price range: ₹1,100.00 through ₹6,125.00
You’re now subscribed to price tracking for this product. We’ll notify you if the price drops.
Boost your energy, stamina, and immunity with our premium Cordyceps mushroom powder (Keeda Jadi) powder. Sourced from lab-grown, high-quality cultures, this 100% natural mushroom supplement is rich in cordycepin and adenosine—compounds known for enhancing respiratory health, endurance, and overall vitality.
Ideal for daily wellness, athletic performance, or traditional Ayurvedic uses, our Cordyceps powder is finely milled, chemical-free, and ready to mix with water, smoothies, or tea.
✅ Pure & potent
✅ Lab-tested for quality
✅ Vegan, gluten-free, no additives
Features: Cordyceps militaris Keeda Jadi mushroom
1. Proudly cultivated at our lab Agripie Agrosystem on rice, milk protein casein and other VEG ONLY media components only.
2. Cordyceps mushroom increases efficacy of Chemo and Radiotheray treatments of Cancer. Energizes body, improves digestion, rebuilds gut microbiota and helps faster recovery.
3. Excellent stress buster and anti-inflammatory effects, rebuilds gut microbiome. Increases cognitive performance. May be useful in Autism and Alzheimer diseases.
4. Best quality Cordyceps militaris mushroom, Crunch and Brittle High Cordycepin and Protein content, most effective.
5. Essential for overall well being in today’s environment of stress, pollution, frequent diseases, etc,
Only logged in customers who have purchased this product may leave a review.

Reviews
There are no reviews yet.